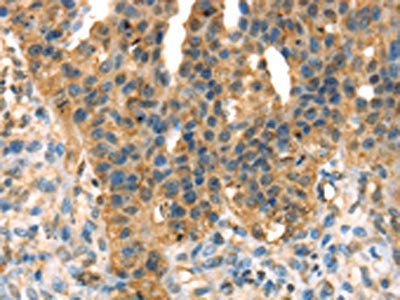

DHCR24 Antibody
-
中文名稱:DHCR24兔多克隆抗體
-
貨號(hào):CSB-PA663869
-
規(guī)格:¥1100
-
圖片:
-
The image on the left is immunohistochemistry of paraffin-embedded Human breast cancer tissue using CSB-PA663869(DHCR24 Antibody) at dilution 1/35, on the right is treated with fusion protein. (Original magnification: ×200)
-
The image on the left is immunohistochemistry of paraffin-embedded Human thyroid cancer tissue using CSB-PA663869(DHCR24 Antibody) at dilution 1/35, on the right is treated with fusion protein. (Original magnification: ×200)
-
Gel: 8%SDS-PAGE, Lysate: 80 μg, Lane: Mouse brain tissue, Primary antibody: CSB-PA663869(DHCR24 Antibody) at dilution 1/400 dilution, Secondary antibody: Goat anti rabbit IgG at 1/8000 dilution, Exposure time: 5 seconds
-
-
其他:
產(chǎn)品詳情
-
Uniprot No.:
-
基因名:DHCR24
-
別名:24 dehydrocholesterol reductase antibody; 24-dehydrocholesterol reductase antibody; 3 beta hydroxysterol delta 24 reductase antibody; 3-beta-hydroxysterol delta-24-reductase antibody; DCE antibody; Delta(24)-sterol reductase antibody; Desmosterol to cholesterol enzyme antibody; DHC24_HUMAN antibody; Dhcr24 antibody; Diminuto dwarf1 homolog antibody; Diminuto/dwarf1 homolog antibody; KIAA0018 antibody; Nbla03646 antibody; Seladin-1 antibody; SELADIN1 antibody; Selective AD indicator 1 antibody; Selective Alzheimer's Disease Indicator 1 antibody
-
宿主:Rabbit
-
反應(yīng)種屬:Human,Mouse,Rat
-
免疫原:Fusion protein of Human DHCR24
-
免疫原種屬:Homo sapiens (Human)
-
標(biāo)記方式:Non-conjugated
-
抗體亞型:IgG
-
純化方式:Antigen affinity purification
-
濃度:It differs from different batches. Please contact us to confirm it.
-
保存緩沖液:-20°C, pH7.4 PBS, 0.05% NaN3, 40% Glycerol
-
產(chǎn)品提供形式:Liquid
-
應(yīng)用范圍:ELISA,WB,IHC
-
推薦稀釋比:
Application Recommended Dilution ELISA 1:2000-1:5000 WB 1:500-1:2000 IHC 1:25-1:100 -
Protocols:
-
儲(chǔ)存條件:Upon receipt, store at -20°C or -80°C. Avoid repeated freeze.
-
貨期:Basically, we can dispatch the products out in 1-3 working days after receiving your orders. Delivery time maybe differs from different purchasing way or location, please kindly consult your local distributors for specific delivery time.
-
用途:For Research Use Only. Not for use in diagnostic or therapeutic procedures.
相關(guān)產(chǎn)品
靶點(diǎn)詳情
-
功能:Catalyzes the reduction of the delta-24 double bond of sterol intermediates during cholesterol biosynthesis. In addition to its cholesterol-synthesizing activity, can protect cells from oxidative stress by reducing caspase 3 activity during apoptosis induced by oxidative stress. Also protects against amyloid-beta peptide-induced apoptosis.
-
基因功能參考文獻(xiàn):
- The crucial role of the insulin/STAT3/DHCR24/PGR axis in the progression of endometrial carcinoma. PMID: 28112250
- DHCR24 might be a therapeutic target for patients with bladder cancer PMID: 30278482
- Mutation in DHCR24 gene cause desmosterolosis presenting with multiple congenital anomalies with increased level of the cholesterol precursor desmosterol while disrupting development of cholesterol, impacting embryogenesis. PMID: 29175559
- Study observed decreased methylation at the DHCR24 locus in offspring of women with active pregnancy eating disorders (ED) and increased methylation at the LGALS2 locus in offspring of women with past ED compared to controls. PMID: 29093763
- the expanding database of post-translational modifications will be a valuable resource for mapping the topology of membrane-associated proteins, such as DHCR24, that is, flagging cytosolic residues accessible to modifying enzymes such as kinases and ubiquitin ligases. PMID: 27919032
- DHCR24 auto-antibody represents a potential noninvasive biomarker for hepatitis C virus-related liver disease and may facilitate the diagnosis of PIVKA-II and AFP-negative hepatocellular carcinoma. PMID: 26288822
- In vitro experiments showed that DHCR24 overexpression induced tumor proliferation. PMID: 24562935
- Data (including data from studies using RNA from post-mortem brain tissue) suggest that expression of DHCR24 is up-regulated in parietal cortex of patients with Huntington's disease as compared to control subjects. PMID: 24916565
- Data indicate a mechanism whereby 3beta-hydroxysterol Delta24-reductase (DHCR24) activity is regulated by signaling. PMID: 24363437
- DHCR24 expression protects neuronal cells from apoptotic cell death induced by endoplasmic reticulum stress. PMID: 24489783
- TR-beta and LXR-alpha competitively up-regulate the human Seladin-1 promoter, sharing the same response element, site A. PMID: 23416078
- DHCR24 gene expression is regulation by cholesterol availability. PMID: 23050906
- Inflammation is inhibited in coronary artery endothlial cells by increasing 3beta-hydroxysteroid-Delta24 reductase expression. PMID: 23123430
- a novel role for 24,25EC in cholesterol homeostasis, through its rapid inhibition of cholesterol synthesis at DHCR24. PMID: 22178193
- a gender dependent effect of DHCR24 rs600491 polymorphism on the susceptibility to Alzheimer disease. PMID: 22910610
- Activation of Sp1 by oxidative stress is involved in the promotion of expression of DHCR24 by Hepatitis C virus. PMID: 22431021
- This study describes Simvastatin modulates the Alzheimer's disease-related gene seladin-1. PMID: 21987590
- DHCR24-overexpressed cells were protected from apoptosis in response to oxidative stress, which was accompanied by a decrease in DHCR24 content on the ER and activation of caspase-3. PMID: 22010141
- affected individuals have a homozygous missense mutation in DHCR24 leading to dramatically augmented plasma desmosterol levels. We thus establish a clear consistent phenotype of desmosterolosis (MIM 602398). PMID: 21559050
- Level of brain amyloid deposition on [(11)C]PiB PET was associated with rs7551288, an intronic SNP in DHCR24, in 103 participants. The minor allele was associated with lower PiB uptake with non-carriers showing higher PiB uptake in frontal regions. PMID: 21901424
- DNA methylation and histone acetylation have roles in regulating the promoter region of the human DHCR24 gene PMID: 20568014
- Promoter methylation could be involved in the altered pattern of seladin-1 gene expression in adrenal carcinoma. PMID: 20465827
- Reduced expression of the enzyme that converts desmosterol into cholesterol, Alzheimer indicator 1 gene (seladin-1/dhcr24), in cortex and cerebellum may underlie increased desmosterol levels in 21 month-old amyloid-beta mutant mice. PMID: 20061631
- Seladin-1 involvement in proliferation and secretion suggests that its downregulation may be a major mechanism causing prostate cancer evolution. PMID: 20166102
- seladin-1/DHCR24 is modulated by the ACTH/cAMP-driven pathway and its expression is reduced in adrenal cancer PMID: 15001630
- unanticipated role for Seladin-1, previously implicated in Alzheimer's disease and cholesterol metabolism, in integrating cellular response to oncogenic and oxidative stress PMID: 15577914
- High levels of DHCR24 gene expression is associated with melanoma metastases PMID: 15688385
- seladin-1 has been isolated and found to be down-regulated in brain regions affected by Alzheimer disease--REVIEW PMID: 15954227
- These original results demonstrate for the first time that seladin-1 is abundantly expressed by stem cells and appear to suggest that reduced expression in AD might be due to an altered pool of multipotent cells. PMID: 16762343
- DHCR24 gene may be associated with Alzheimer's disease risk. PMID: 17510943
- Preliminary results suggest the absence of an association between DHCR24/seladin-1 genotypes and Alzheimer's disease in the Italian population. PMID: 17579359
- ablation of DHCR24/seladin-1 prevented apoptosis of primary neurons in a p53-dependent manner PMID: 17984220
- DHCR24 protects neuroblastoma cells against Abeta toxicity by increasing membrane cholesterol content. PMID: 18194465
- Seladin-1 may be considered a fundamental mediator of the neuroprotective effects of estrogen. PMID: 18499757
- the seladin-1 gene is androgen regulated and has a higher level of expression in prostate cancer tissues compared to the normal prostate PMID: 18762779
- Seladin-1/DHCR24 is an LXR target gene and that LXR may regulate lipid raft formation. PMID: 18815215
- Results suggest that antiinflammatory effects of HDLs are mediated partly through an upregulation of DHCR24. PMID: 19325144
- seladin-1 expression and intracellular localization are correlated with both the intensity and nature of ACTH-induced steroidogenesis and resultant oxidative stress. PMID: 19520779
- seladin-1 downregulation increases BACE1 levels and activity through enhanced GGA3 depletion during apoptosis PMID: 19815556
- DHCR24 is elevated in response to HCV infection and inhibits the p53 stress response by stimulating the accumulation of the MDM2-p53 complex in the cytoplasm and by inhibiting the acetylation of p53 in the nucleus. PMID: 19861417
顯示更多
收起更多
-
相關(guān)疾病:Desmosterolosis (DESMOS)
-
亞細(xì)胞定位:Endoplasmic reticulum membrane; Single-pass membrane protein. Golgi apparatus membrane; Single-pass membrane protein.
-
蛋白家族:FAD-binding oxidoreductase/transferase type 4 family
-
組織特異性:Highly expressed in brain and adrenal gland with moderate expression in liver, lung, spleen, prostate and spinal cord. Low expression in heart, uterus and prostate. Undetectable in blood cells. In the brain, strongly expressed in cortical regions, substan
-
數(shù)據(jù)庫(kù)鏈接: